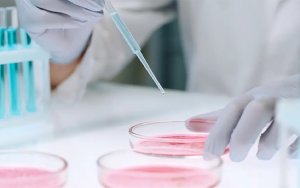

CÁC BIẾN CHỨNG NGUY HIỂM DO BỆNH TIỂU ĐƯỜNG GÂY RA?
Lượng carbohydrate chúng ta hấp thụ hàng ngày được chuyển vào ruột dưới dạng glucose và hòa tan vào máu. Lúc này hormone insulin được tiết ra từ tuyến tụy và chuyển hóa carbohydrate thành glucose và trở thành nguồn năng lượng cho cơ thế. Khi insulin bị rối loạn hoặc lượng glucose tăng cao đến mức insulin không thể xử lý được nữa, lượng glucose dư thừa trong máu không thể chuyển hóa thành nguồn năng lượng, gây ra bệnh tiểu đường hay còn gọi là đái tháo đường.

Một số biến chứng nguy hiểm do bệnh tiểu đường gây ra:
– Bệnh nhãn khoa: đục thủy tinh thể, tăng nhãn áp, trầy xước giác mạc,…
– Lở loét tứ chi, trường hợp nặng bị hoại tử cần cắt bỏ
– Bệnh gan mật: gan nhiễm mỡ, xơ gan,…
– Bệnh ung thư: ung thư gan, ung thư tuyến tụy, ung thư thận,…
– Bệnh tim mạch
KHÁI NIỆM TẾ BÀO GỐC
Tế bào gốc là một trong những thành tựu y học đáng kinh ngạc trong vòng một thế kỳ qua, đang được nghiên cứu và ứng dụng mạnh mẽ tại Nhật Bản và nhiều quốc gia phát triển trên thế giới.
Đặc biệt là giải Nobel Y học 2012 của nhà khoa học John Gurdon và Shinya Yamanaka đã phát hiện ra Tế bào gốc trưởng thành có thể được tái lập trình về di truyền học để trở thành một tế bào giống Tế bào gốc đa năng.
2 KHẢ NĂNG TUYỆT VỜI CỦA TẾ BÀO GỐC
Các tế bào gốc tái tạo và bổ sung các tế bào tồn tại trong thời gian ngắn và hoạt động khi các mô của cơ thể cần sửa chữa, chẳng hạn như khi bị tổn thương hoặc bị bệnh. Có 2 khả năng của tế bào gốc đóng vai trò quan trọng như vậy:
- Khả năng tự sao chép là các tế bào phân chia và tạo ra các tế bào giống như chính mình.
- Hiệu ứng Homing là khả năng các tế bào gốc được giải phóng vào cơ thể để tìm vị trí cần tái tạo. Theo tín hiệu của cơ thể, tế bào gốc sẽ ưu tiên sửa chữa, tái tạo các tế bào liên quan đến sự sống của cơ thể trước, sau đó là các tế bào chức năng khác.

CƠ CHẾ HOẠT ĐỘNG CỦA TẾ BÀO GỐC GIÚP ĐIỀU TRỊ BỆNH TIỂU ĐƯỜNG NHƯ THẾ NÀO?
Với khả năng đặc biệt là tự đổi mới, tăng sinh và biệt hóa thành các tế bào khác trong cơ thể, tế bào gốc khi được tiêm vào cơ thể sẽ hình thành các tế bào mới có chức năng hấp thụ glucose một cách trực tiếp mà không cần đến insulin, nhờ đó giúp người bệnh có thể kiểm soát ổn định lượng đường trong máu và hạn chế được việc sử dụng insulin hoặc không cần phụ thuộc vào nó nữa.
Các nghiên cứu hiện nay cho thấy phương pháp Tế bào gốc trong điều trị bệnh tiểu đường có thể mang đến hiệu quả kéo dài cho đến 5 năm, mang đến hy vọng mới cho người bị tiểu đường. Tuy nhiên đó cũng chính là thách thức cho nền y học, bởi sự hiệu quả vượt trội trong điều trị bệnh, phương pháp Tế bào gốc đòi hỏi đội ngũ bác sĩ chuyên môn cao và cần phải được cấp phép của chính phủ mới có thể thực hiện liệu pháp này. Hiện nay tại Nhật Bản, chỉ một số ít cơ sở y tế được Chính phủ cấp phép cho thực hiện phương pháp này. Vì vậy, người bệnh cần lựa chọn thật kỹ cơ sở y tế uy tín để điều trị.
SO SÁNH PHƯƠNG PHÁP ĐIỀU TRỊ TIỂU ĐƯỜNG BẰNG CÁC PHƯƠNG PHÁP THÔNG THƯỜNG VÀ PHƯƠNG PHÁP TẾ BÀO GỐC
Phương pháp thông thường
– Điều trị bằng cách uống thuốc hoặc tiêm insulin gây bất tiện cho người bệnh.
– Không thể chữa khỏi hoàn toàn, dẫn đến nhiều biến chứng nguy hiểm liên quan đến các bệnh lý như mỡ máu, tim mạch, mù lòa, hoại tử tứ chi, ung thư…
– Điều trị kéo dài dai dẳng khiến người bệnh kiệt sức, chán nản, ăn không ngon ngủ không yên, bệnh càng thêm bệnh.
Phương pháp tế bào gốc
– Không đau đớn, không phẫu thuật, không cần uống thuốc mỗi ngày
– Ngăn ngừa nguy cơ bị biến chứng dẫn đến các bệnh lý nguy hiểm.
– Điều trị nhanh chóng, có hiệu quả ngay lập tức sau mỗi lần tiêm.

Điều trị tiểu đường bằng tế bào gốc mở ra cánh cửa hy vọng cho người bệnh tiểu đường trong công cuộc tìm kiếm cuộc sống không phụ thuộc vào insulin.
Liên hệ ngay với MHC để được hỗ trợ:
Hotline: 0825.255.986
Email: info@miraihealthcare.com
Trụ sở: 25 Mạc Thái Tông, Trung Hòa, Cầu Giấy, Hà Nội

